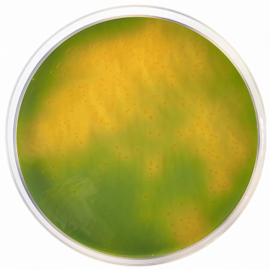

Môi trường vi sinh Thiosulfate Citrate Bile Saccharose (TCBS) Agar
Principles and uses
TCBS Agar is a selective medium widely used to isolate and cultivate practically all bacteria of the genus Vibrio, including V. cholerae and V. alginolyticus, pathogenic to humans causing cholera, choleral diarrhea or food poisoning from contaminated foods and from stool specimens. The last 2
conditions especially can be caused by ingesting raw or partially processed fish or seafood containing Vibrio parahemolyticus. The only Vibrio that does not grow in TCBS is V. hollisae.
The meat and casein peptones provide nitrogen, vitamins, minerals and amino acids essential for growth. Yeast extract is a source of vitamins, particularly of the B-group. Sodium citrate, sodium thiosulfate and ox bile are the selective agents, inhibiting the Gram positive bacteria. Sodium
thiosulfate provides sulphur, and ferric citrate is the indicator for H2S production. Sucrose is the carbohydrate energy source. Bromothymol blue and thymol blue are pH indicators. Sodium chloride promotes growth (Vibrio grows well in salty media). Bacteriological agar is the solidifying agent. The alkaline pH of the medium enhances the recovery of V. cholerae.
Sucrose-positive vibrios, such as Vibrio cholerae and Vibrio alginolyticus, are yellow on TCBS. Sucrose-negative ones, such as Vibrio parahaemolyticus and Vibrio vulnificus, produce blue- green colonies. Almost all Vibrio ferment sucrose and yield yellow colonies from the production of acid. Some types of Proteus (fermenters of sucrose) can form yellow colonies similar to those of Vibrio.
Preparation
Suspend 88 grams of the medium in one liter of distilled water. Mix well. Dissolve by heating with frequent agitation. Boil for one minute until complete dissolution. DO NOT OVEARHEAT. DO NOT AUTOCLAVE. Cool to 50 ºC, mix well and dispense into plates.